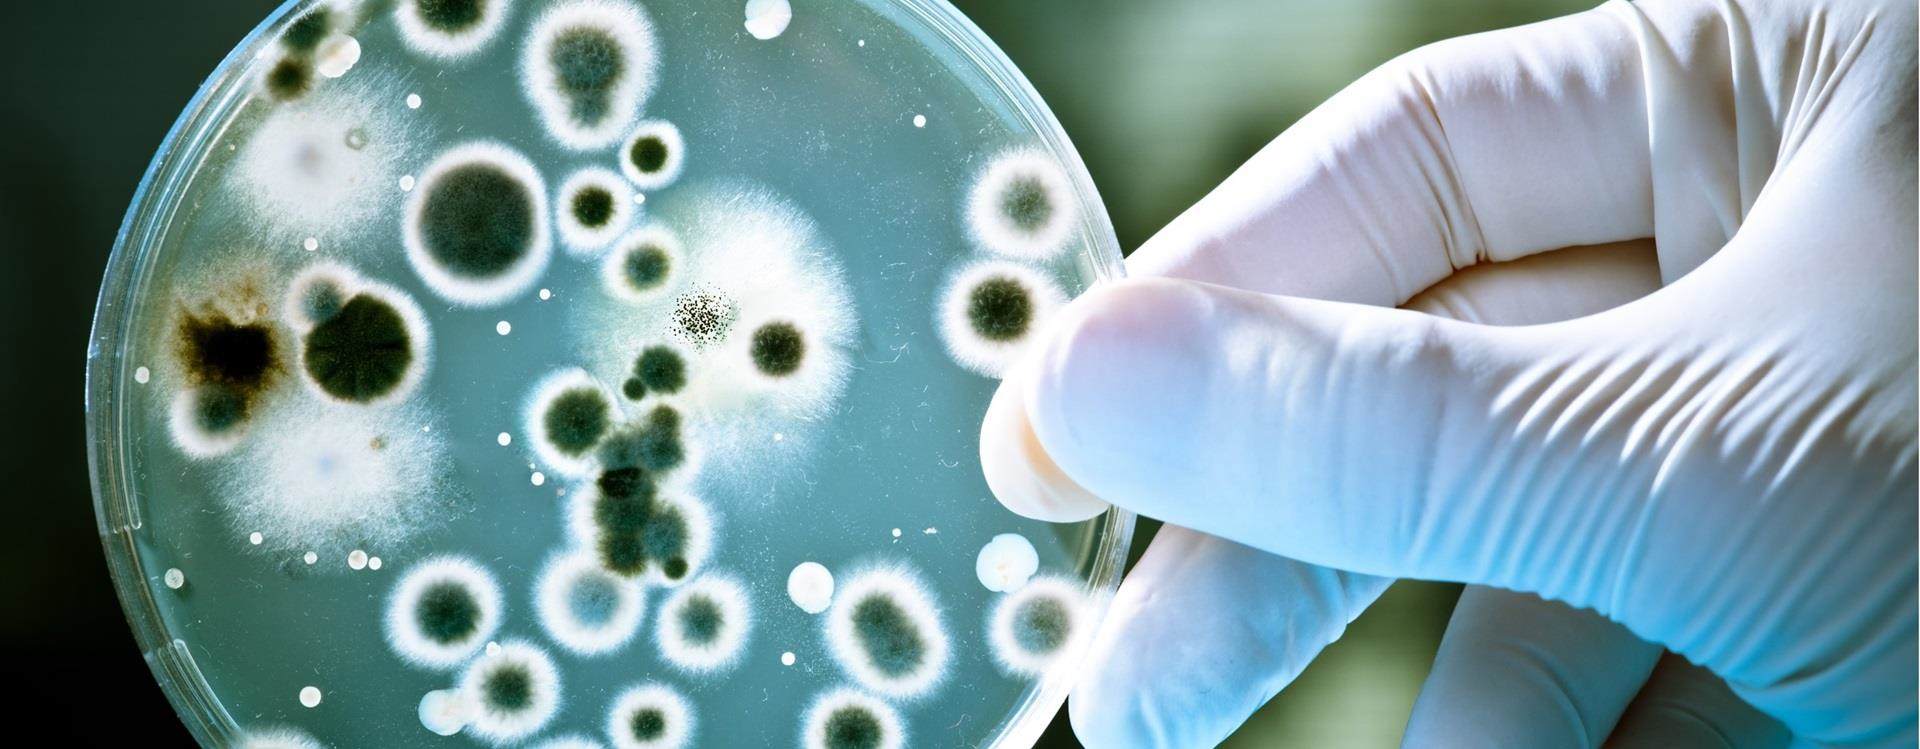

Croda’s first product launch specifically focusing on the biopesticide market
Croda has launched the new product Atlox™ BS-50, a ready-to-use wettable powder (WP) delivery system which specifically meets the needs of the growing biopesticide market.
With the shift in agriculture towards more sustainable products, biopesticides derived from natural materials are being widely explored as a credible option. The challenge with using agricultural microbes, a class of biopesticides, is developing a suitable formulation system that provides the right environment for a microbe to survive but also maintain the performance requirements that a formulation has (such as no separation or sedimentation in storage).
Atlox BS-50 is a ready-to-use powder delivery system for spore forming microbes. Its simplicity in use means only the addition of the microbe is required to complete the final microbial WP formulation, thus reducing development time. Components of Atlox BS-50 have been carefully optimised by Croda’s scientists to provide the best performance and have undergone viability testing to ensure they are compatible with common microbes, and therefore providing versatility for its use.
Erik-Jan Bartels, Managing Director Croda Crop Protection and Incotec Seed Enhancement, said:
“We are very excited about this new product launch. We already have a portfolio of delivery systems that are being used for both conventional and biopesticides but this is the first product we have developed specifically for biopesticides, a key strategic area for us. Biopesticides are growing much faster than conventional pesticides and we are bringing new innovation to the market to seize this opportunity. Our new Atlox BS-50 product is part of Croda’s innovative portfolio of agricultural technologies that are helping to shape a sustainable future for agriculture.”
Atlox BS-50 is a ready-to-use powder delivery system for spore forming microbes. Its simplicity in use means only the addition of the microbe is required to complete the final microbial WP formulation, thus reducing development time. Components of Atlox BS-50 have been carefully optimised by Croda’s scientists to provide the best performance and have undergone viability testing to ensure they are compatible with common microbes, and therefore providing versatility for its use.
Erik-Jan Bartels, Managing Director Croda Crop Protection and Incotec Seed Enhancement, said:
“We are very excited about this new product launch. We already have a portfolio of delivery systems that are being used for both conventional and biopesticides but this is the first product we have developed specifically for biopesticides, a key strategic area for us. Biopesticides are growing much faster than conventional pesticides and we are bringing new innovation to the market to seize this opportunity. Our new Atlox BS-50 product is part of Croda’s innovative portfolio of agricultural technologies that are helping to shape a sustainable future for agriculture.”
Atlox BS-50

672.4 KB
Login to download
Download
Want to find out more?